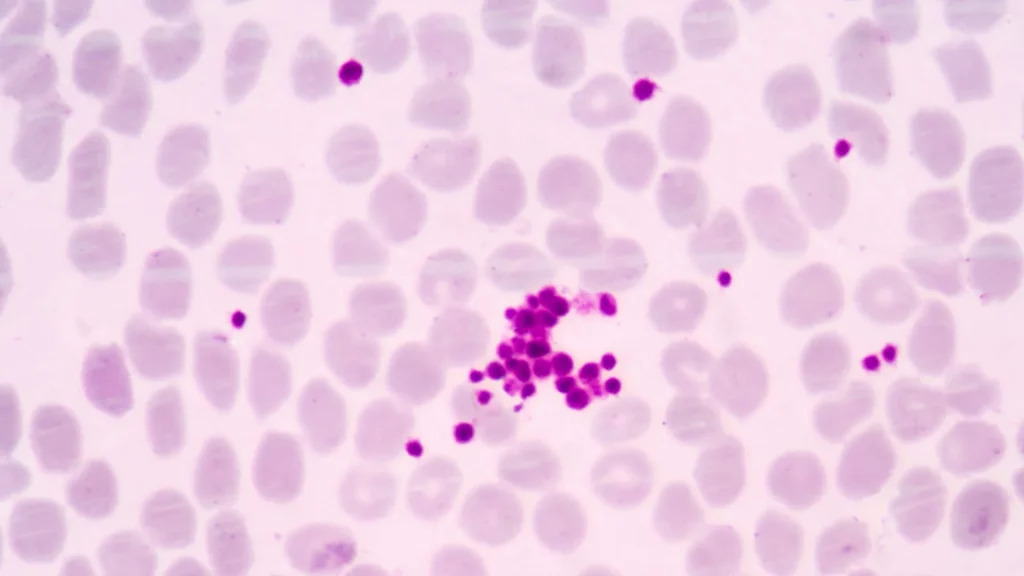
Dalam pemeriksaan sitologi urin, pemilihan metode penyimpanan sampel sangat menentukan kualitas hasil analisis.

Dalam pemeriksaan sitologi urin, pemilihan metode penyimpanan sampel sangat menentukan kualitas hasil analisis. Dua pendekatan yang umum digunakan adalah penggunaan fixative dan non-fixative. Masing-masing memiliki kelebihan dan kekurangan yang perlu dipahami sebelum diterapkan dalam praktik klinis.
Konsep Fixative dalam Sitologi
Fixative adalah zat kimia yang ditambahkan ke dalam sampel urin untuk mempertahankan struktur sel dan mencegah degradasi. Dengan adanya fixative, sel-sel urin lebih stabil ketika diamati di bawah mikroskop, sehingga hasil diagnosis lebih akurat.
Metode Non-Fixative
Sebaliknya, metode non-fixative mengandalkan analisis langsung sampel urin tanpa penambahan zat pengawet. Cara ini lebih cepat dan sederhana, namun rentan terhadap perubahan sel akibat waktu, suhu, maupun kontaminasi bakteri.
Kelebihan Menggunakan Fixative
Fixative memastikan bahwa morfologi sel tetap terjaga hingga sampel diperiksa. Hal ini sangat bermanfaat ketika sampel harus dikirim ke laboratorium jauh atau disimpan dalam waktu lama sebelum analisis dilakukan.
Kekurangan Fixative
Meskipun efektif, penggunaan fixative memiliki beberapa kekurangan. Beberapa jenis fixative bisa bersifat toksik, memengaruhi kualitas pewarnaan, atau tidak cocok untuk analisis molekuler tertentu. Hal ini perlu menjadi pertimbangan dalam pemilihan.
Kelebihan Non-Fixative
Metode non-fixative lebih praktis karena tidak membutuhkan tambahan bahan kimia. Proses pengumpulan sampel lebih cepat, aman bagi pasien, dan sesuai untuk pemeriksaan segera di fasilitas kesehatan yang memiliki akses langsung ke laboratorium.
Kekurangan Non-Fixative
Namun, tanpa fixative, sel dalam urin dapat cepat rusak. Enzim dan bakteri dalam urin dapat menghancurkan detail morfologi sel hanya dalam hitungan jam, sehingga berisiko menghasilkan interpretasi yang salah.
Fixative untuk Analisis Jangka Panjang
Fixative lebih unggul jika tujuan pemeriksaan membutuhkan penyimpanan jangka panjang atau transportasi ke laboratorium rujukan. Keutuhan sel tetap terjaga meski sampel melewati waktu dan jarak yang panjang.
Non-Fixative untuk Analisis Cepat
Metode non-fixative lebih cocok untuk pemeriksaan segera di rumah sakit atau klinik dengan fasilitas lengkap. Dalam situasi ini, sampel dapat langsung diproses sehingga risiko kerusakan sel sangat minimal.
Dampak terhadap Hasil Diagnosis
Pemilihan fixative atau non-fixative berpengaruh langsung pada kualitas hasil sitologi. Fixative meningkatkan akurasi dalam kasus kanker kandung kemih atau kelainan sel lain, sementara non-fixative bisa cukup untuk skrining awal pada pasien tertentu.
Pertimbangan Biaya
Penggunaan fixative tentu menambah biaya operasional karena memerlukan bahan tambahan. Sebaliknya, metode non-fixative lebih hemat, namun berisiko menurunkan kualitas jika tidak segera dianalisis.
Pertimbangan Keamanan
Aspek keamanan juga menjadi faktor penting. Beberapa fixative, seperti formalin, bersifat toksik dan memerlukan prosedur keselamatan khusus. Non-fixative lebih aman dari sisi penanganan, tetapi memiliki keterbatasan teknis.
Kombinasi Fixative dan Non-Fixative
Dalam praktiknya, beberapa laboratorium menggunakan kombinasi kedua metode. Sebagian sampel diproses segera tanpa fixative, sementara sisanya diberi fixative untuk penyimpanan atau analisis lanjutan.
Kapan Memilih Fixative
Fixative lebih direkomendasikan ketika pemeriksaan sitologi urin digunakan untuk deteksi kanker, infeksi kronis, atau penelitian yang membutuhkan data morfologi sel yang presisi.
Kesimpulan
Baik fixative maupun non-fixative memiliki peran masing-masing dalam sitologi urin. Fixative unggul untuk menjaga kualitas sel jangka panjang, sementara non-fixative lebih praktis untuk analisis cepat. Pemilihan sebaiknya disesuaikan dengan tujuan pemeriksaan, fasilitas yang tersedia, serta kebutuhan klinis pasien.